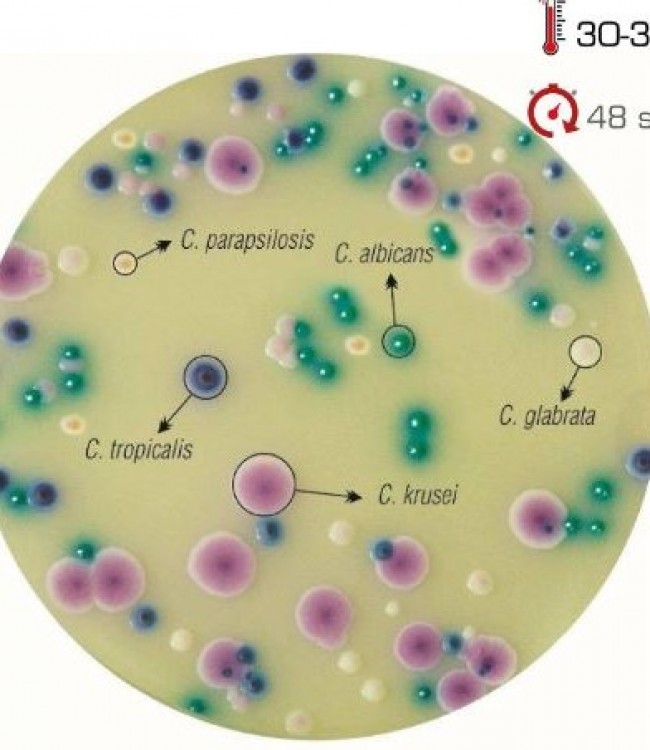
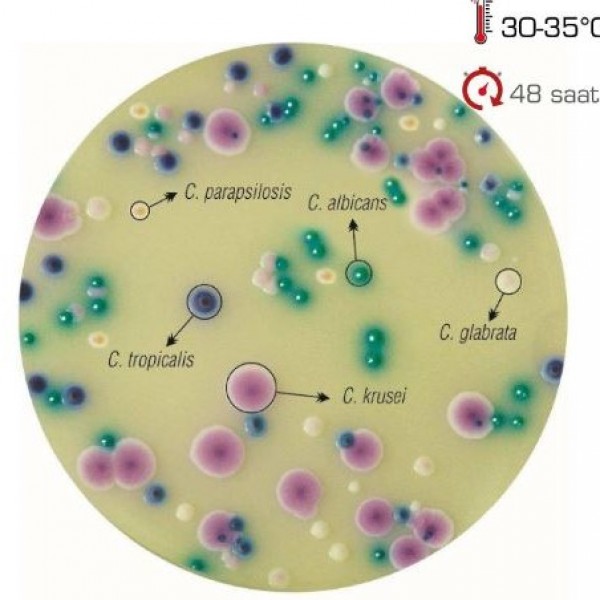

Chromogenic Candida Agar
Chromogenic Candida Agar
Candida türlerinin klinik örneklerden seçici izolasyonu için
kullanılan kromojenik besiyeridir.
C. albicans: nil yeşili, S tipi koloni
C. tropicalis: mavi -mor, agara difüze olan halesi olan S tipi koloni
C. krusei: pembe, pürtüklü, R tipi koloni